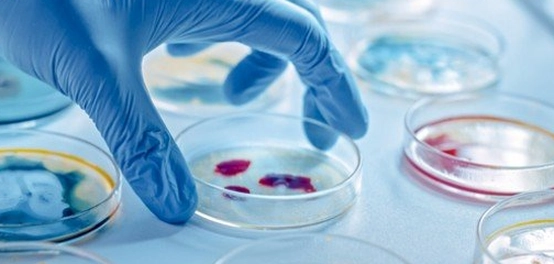

جدول المحتويات
مقدمة عن البكتيريا المثبتة للنيتروجين
البكتيريا المثبتة للنيتروجين، والتي تعرف بالإنجليزية بـ (Azotobacters)، هي جزء من عائلة الأزوتيات (Azotobacteranceae). تتميز هذه البكتيريا بشكلها البيضاوي وحجمها الكبير نسبياً مقارنةً بأنواع البكتيريا الأخرى، حيث يتراوح عرضها بين 1 و3 ميكرومتر، وطولها بين 2 و10 ميكرومتر.
تعتبر هذه البكتيريا سالبة لصبغة جرام وهي من الأنواع الهوائية. تم تحديد ستة أنواع مختلفة من البكتيريا المثبتة للنيتروجين. بعض هذه الأنواع قادر على الحركة بفضل وجود الأسواط، بينما البعض الآخر غير متحرك. تم التعرف على أول هذه الأنواع في عام 1901 بواسطة عالم الأحياء الدقيقة مارتينوس بايرينك، وهي النوع الأول من البكتيريا الهوائية التي تساعد على تثبيت الأكسجين الذي تم اكتشافها في العالم.
تعيش هذه البكتيريا في بيئات متنوعة مثل التربة والماء وجذور النباتات والرواسب.
السمات المميزة للبكتيريا المثبتة للنيتروجين
تمتلك البكتيريا المثبتة للنيتروجين مجموعة من الخصائص المميزة، بما في ذلك كونها غير ذاتية التغذية (Heterotrophic). تتأثر هذه البكتيريا بتغيرات الرقم الهيدروجيني، حيث تفضل البيئات المتعادلة إلى القلوية قليلاً، وتعتبر الدرجة المثلى لها بين 7 و7.5. يؤثر انخفاض أو ارتفاع الرقم الهيدروجيني على وجودها وعددها في التربة.
كما تتأثر البكتيريا المثبتة للنيتروجين بدرجة الحرارة، حيث تعتبر درجة الحرارة المثالية لنموها بين 25 و30 درجة مئوية. قد تتكيف بعض أنواع هذه البكتيريا مع ارتفاع نسبة الملح في التربة، حيث يمكن لبعضها أن يعيش بشكل جيد عند نسبة 10% من الملح، ولكن بشكل عام يزداد تكاثرها وعددها عندما يقل تركيز الملح في التربة.
تنتج بعض أنواع البكتيريا المثبتة للنيتروجين صبغات بألوان مختلفة مثل الأصفر والأخضر والأحمر إلى البنفسجي والبني إلى الأسود. تتواجد هذه البكتيريا بشكل طبيعي في التربة، وتشكل كمية من الوحل وتحبس الماء داخلها. وفي الظروف البيئية القاسية، تشكل البكتيريا المثبتة للنيتروجين تكيسات حولها لحمايتها.
منافع البكتيريا المثبتة للنيتروجين
تساهم البكتيريا المثبتة للنيتروجين في إنتاج السماد الحيوي، الذي يتطلب تواجد العديد من العناصر مثل روث الحيوانات كالأبقار ومسحوق التالك ودودة الأرض ونوع أو أكثر من البكتيريا مثل البكتيريا المثبتة للنيتروجين، أو البكتيريا المستجذرة، أو الطحالب. يساعد هذا السماد على نمو النباتات ويحتوي على العديد من العناصر الغذائية.
كما تساهم هذه البكتيريا في تثبيت النيتروجين في التربة من خلال عملية تسمى (Nitrogenase)، حيث تساعد على تحويل النيتروجين الموجود في الغلاف الجوي إلى أمونيا يمكن للجذور امتصاصها. وخلال هذه العملية تتحول خلايا البكتيريا وجذور النباتات إلى نسيج جديد يسمى العقيدات.
زيادة النيتروجين المقدم للنباتات يؤثر في نموها، كما أن توفيره بهذا الشكل الطبيعي يعني سهولة امتصاصه للنباتات، ويوفر بديلاً للسماد الذي يحتوي على النيتروجين. ووجدت إحدى الدراسات أن المحصول الذي يحتاج إلى 2 طن من السماد الذي يحتوي على النيتروجين المُصنّع يمكن تسميده بطن واحد من النيتروجين الطبيعي، ولكن يجب وجود عناصر أخرى في التربة والمحيط مثل الفوسفات، والموليبدنوم (Molybdenum)، والماء، لإنتاج وتثبيت النيتروجين في التربة.
تتشكل العقديات التي تساعد على تثبيت النيتروجين في العديد من المحاصيل الزراعية ومنها الأرز، والذرة، وقصب السكر، والدخن، والخضار، والمحاصيل الزراعية.
المراجع
- “Azotobacter”,sciencedirect
- “Azotobacter: A potential bio-fertilizer for soil and plant health management”,nih
- “Nitrogen Fixing Azotobacter Species as Potential Soil Biological Enhancers for Crop Nutrition and Yield Stability”,frontiersin
- “Azotobacter Genomes: The Genome of Azotobacter chroococcum NCIMB 8003 (ATCC 4412)”,nih
- “Potential Use of Azotobacter Chroococcum in Crop Production: An Overview”,agriculturejournal